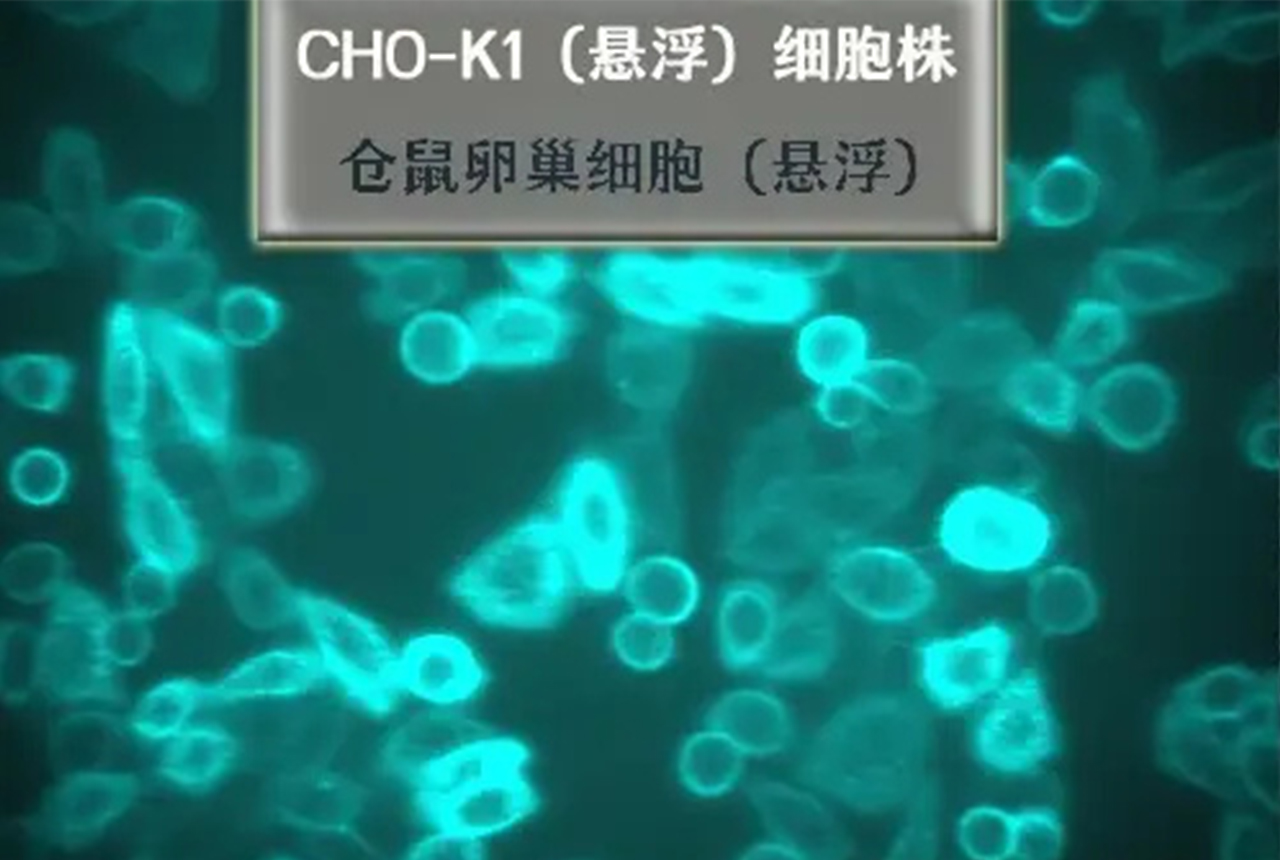
2.jpg

在生物制药领域,哺乳动物细胞被广泛应用于生产重组蛋白、疫苗和抗体等生物制品。其中,中国仓鼠卵巢(CHO)细胞系因其易于培养、遗传背景清晰、生产效率高等优点,成为最常用的哺乳动物细胞系之一。CHO细胞系主要包括CHO-S细胞、CHO-K细胞和CHO-DG44细胞,它们在基因工程、蛋白质表达等方面发挥着重要作用。本文将对这三种细胞系进行对比,探讨它们之间的区别和应用场景。
CHO-S细胞
一、CHO-S细胞
CHO-S细胞是一种非肿瘤性CHO细胞系,由中国科学院上海细胞研究所从CHO细胞中筛选而来。CHO-S细胞具有较高的遗传稳定性,适用于大规模培养和重组蛋白的生产。其优点包括:
1. 遗传稳定性:CHO-S细胞具有较高的遗传稳定性,有利于大规模培养和重组蛋白的生产。
2. 高表达水平:CHO-S细胞能够高效表达外源基因,实现高产量的重组蛋白。
3. 易于培养:CHO-S细胞对培养基要求不高,易于培养和操作。
4. 应用广泛:CHO-S细胞适用于多种重组蛋白的生产,如抗体、疫苗、细胞因子等。
cho-K细胞
二、CHO-K细胞
CHO-K细胞是一种肿瘤性CHO细胞系,由美国科学家从CHO细胞中筛选而来。与CHO-S细胞相比,CHO-K细胞具有以下特点:
1. 无限增殖能力:CHO-K细胞具有无限增殖能力,适用于长期培养和大规模生产。
2. 高表达水平:CHO-K细胞能够高效表达外源基因,实现高产量的重组蛋白。
3. 易于培养:CHO-K细胞对培养基要求不高,易于培养和操作。
4. 应用广泛:CHO-K细胞适用于多种重组蛋白的生产,如抗体、疫苗、细胞因子等。
CHO-DG44
三、CHO-DG44细胞
CHO-DG44细胞是一种具有抗辐射能力的CHO细胞系,由美国科学家从CHO细胞中筛选而来。CHO-DG44细胞的特点如下:
1. 抗辐射能力:CHO-DG44细胞具有抗辐射能力,能够在辐射条件下生长和繁殖。
2. 遗传稳定性:CHO-DG44细胞具有较高的遗传稳定性,有利于大规模培养和重组蛋白的生产。
3. 高表达水平:CHO-DG44细胞能够高效表达外源基因,实现高产量的重组蛋白。
4. 应用广泛:CHO-DG44细胞适用于抗辐射药物的筛选和生产,也可用于其他重组蛋白的生产。
CHO-S细胞、CHO-K细胞和CHO-DG44细胞在生物制药领域具有广泛的应用。 它们在遗传稳定性、表达水平、培养条件等方面具有一定的相似性,但也存在差异。CHO-S细胞和CHO-K细胞适用于大规模培养和重组蛋白的生产,而CHO-DG44细胞具有抗辐射能力,适用于抗辐射药物的筛选和生产。在实际应用中,应根据具体需求选择合适的细胞系。
细胞实验外包 想了解更多请关注:http://www.do-gene.cn

